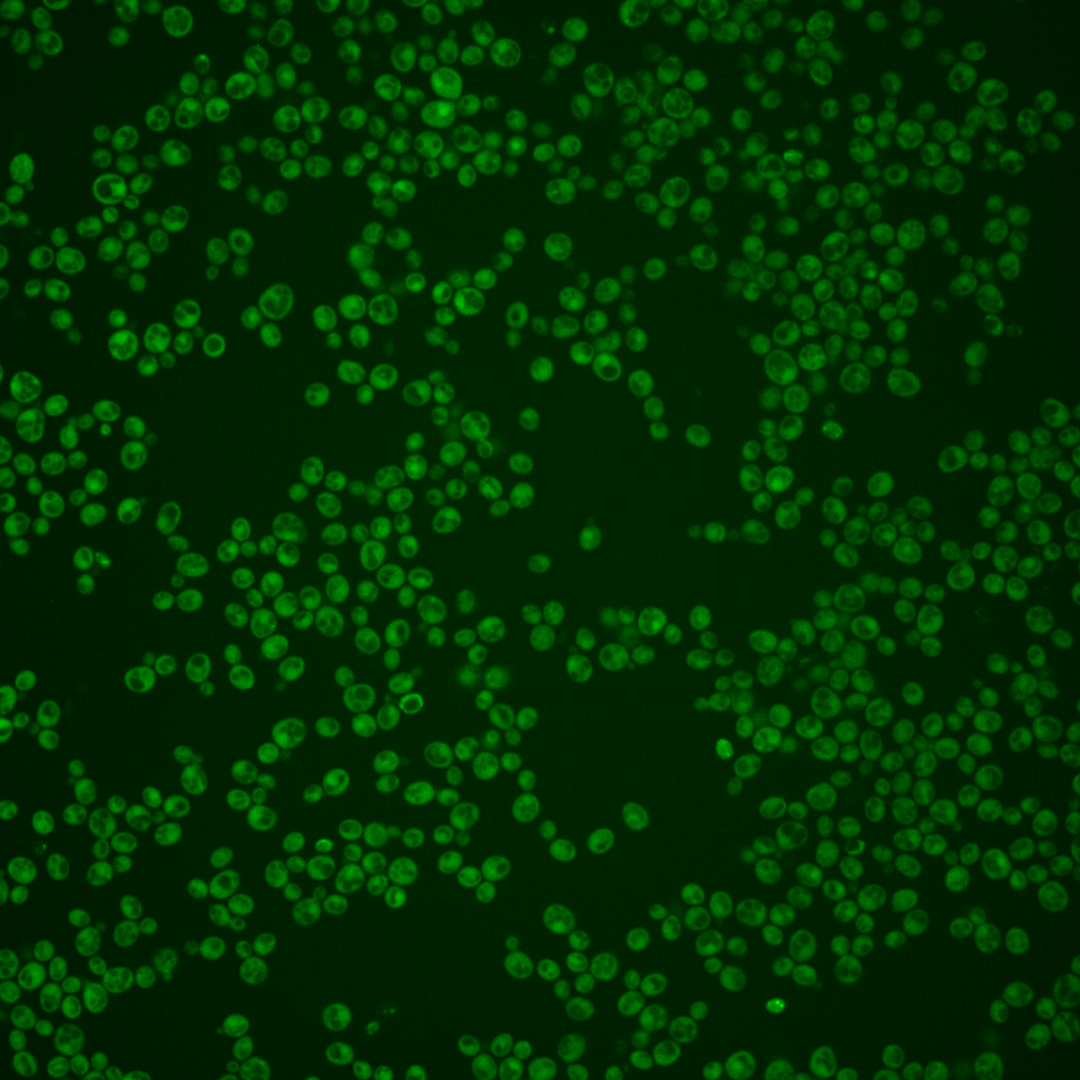
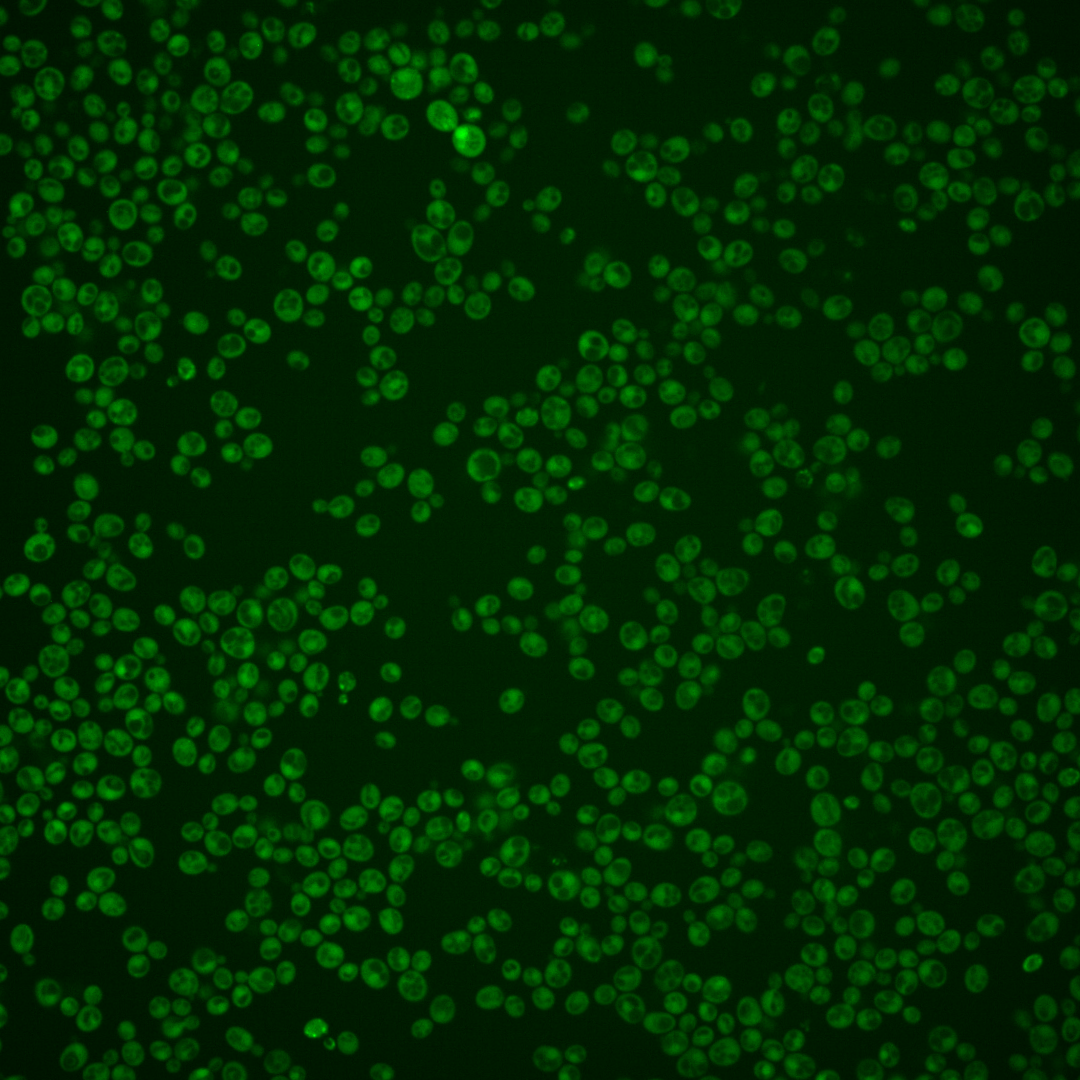
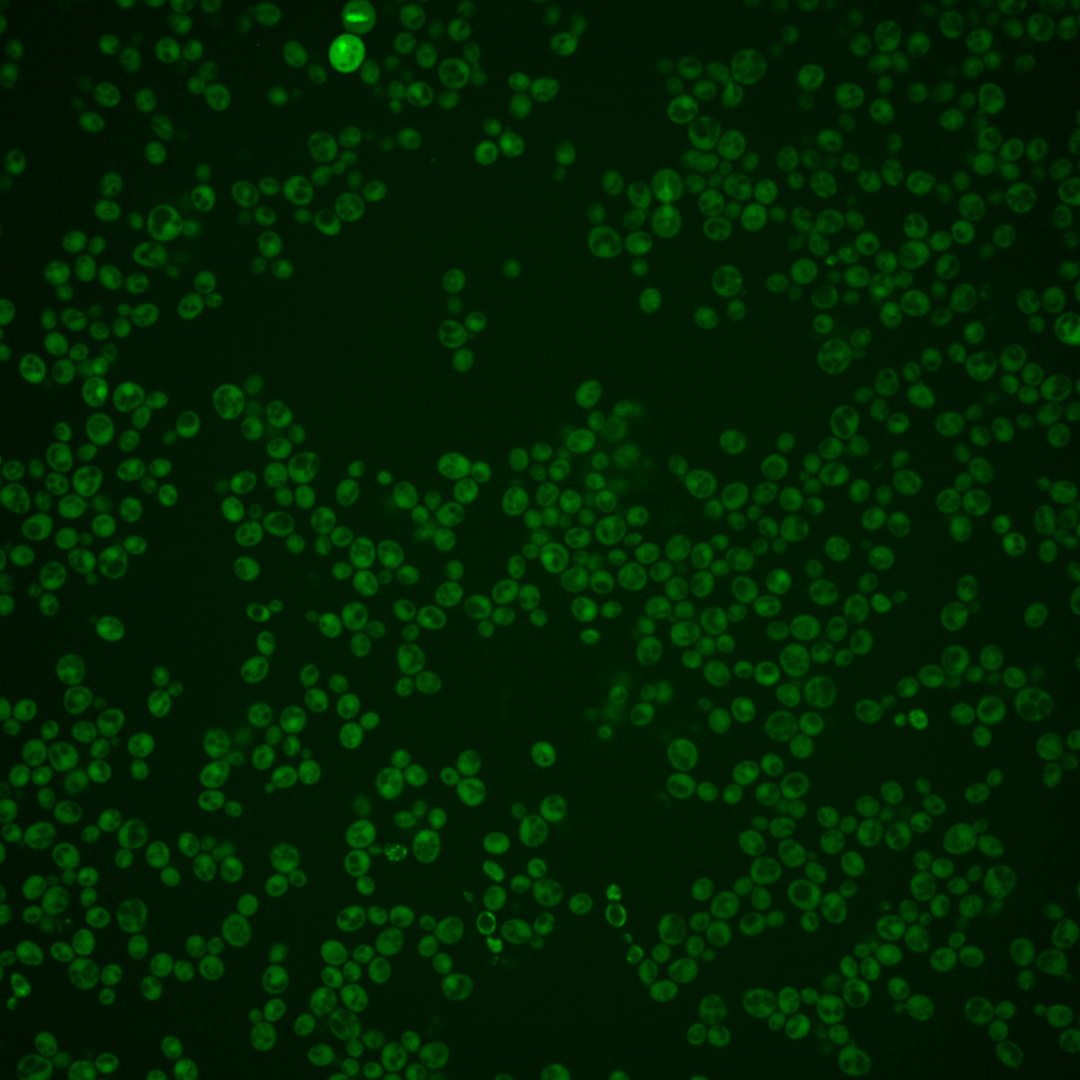
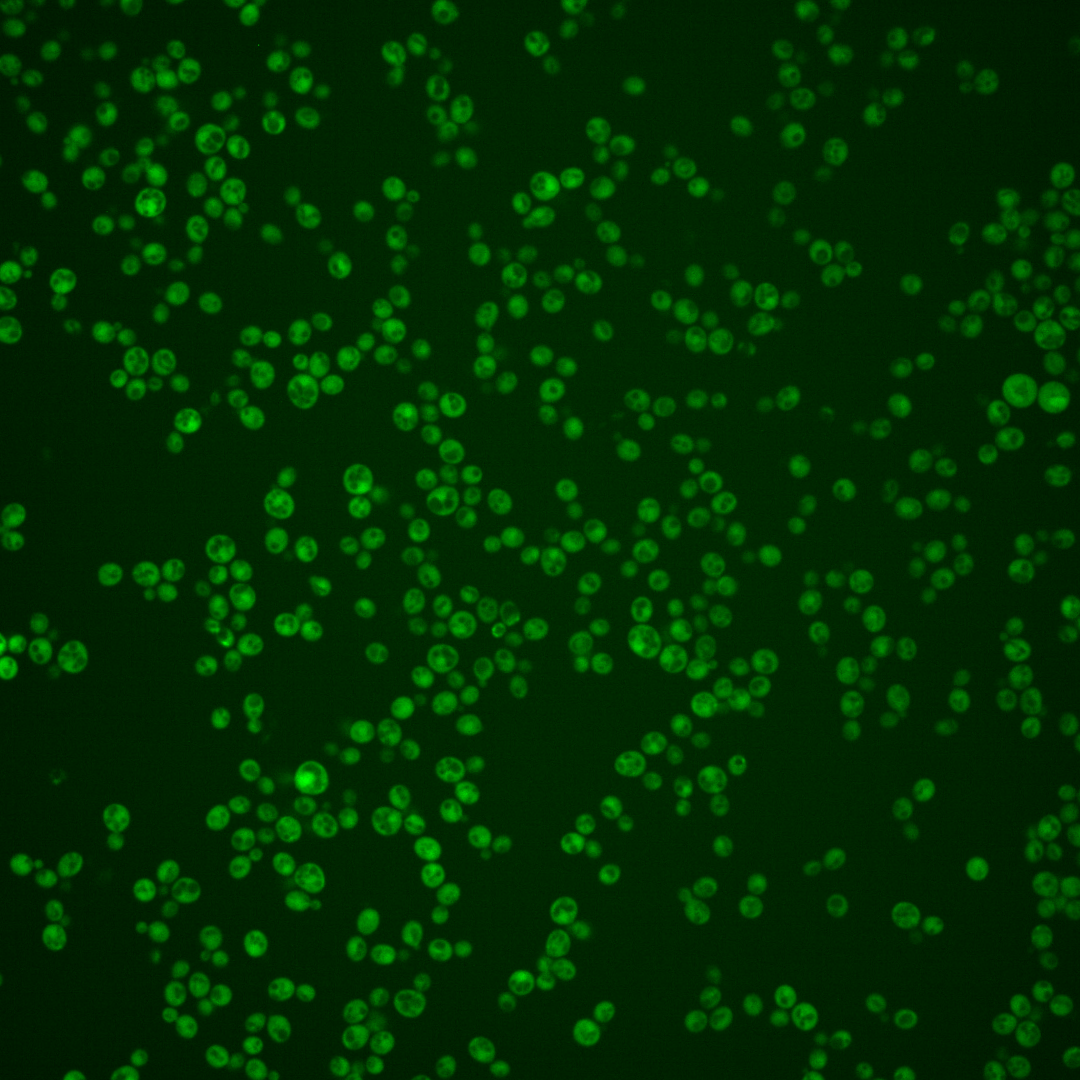
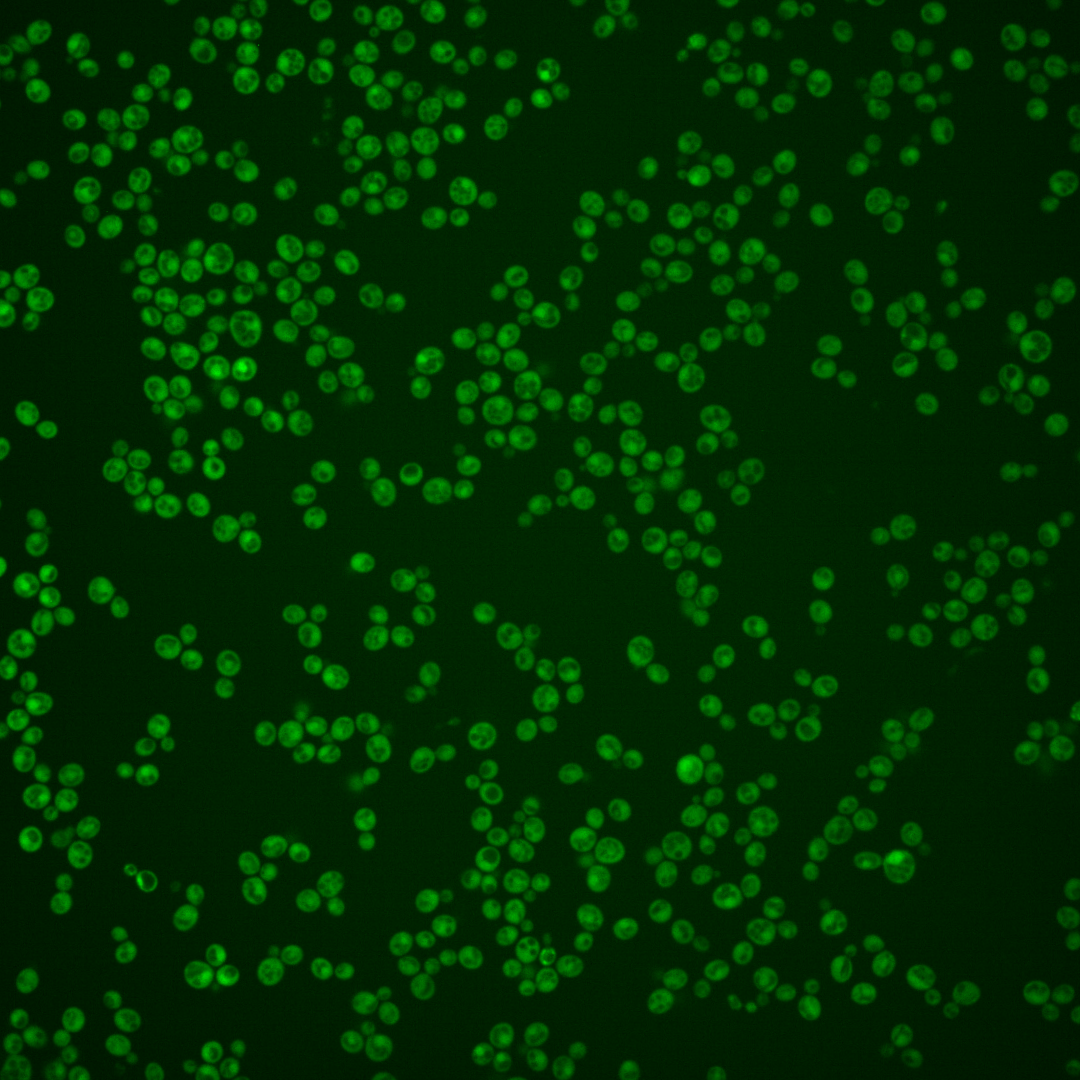
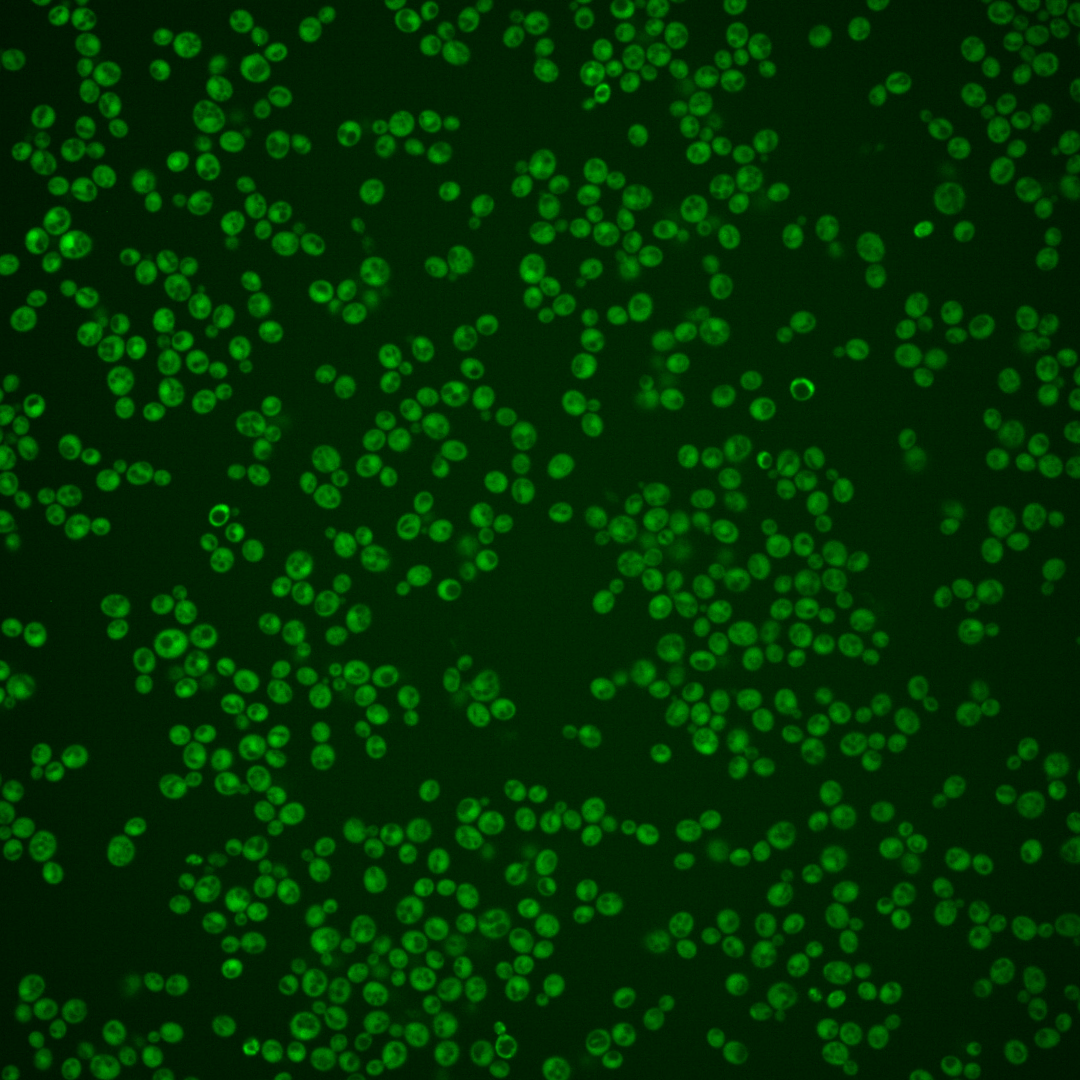
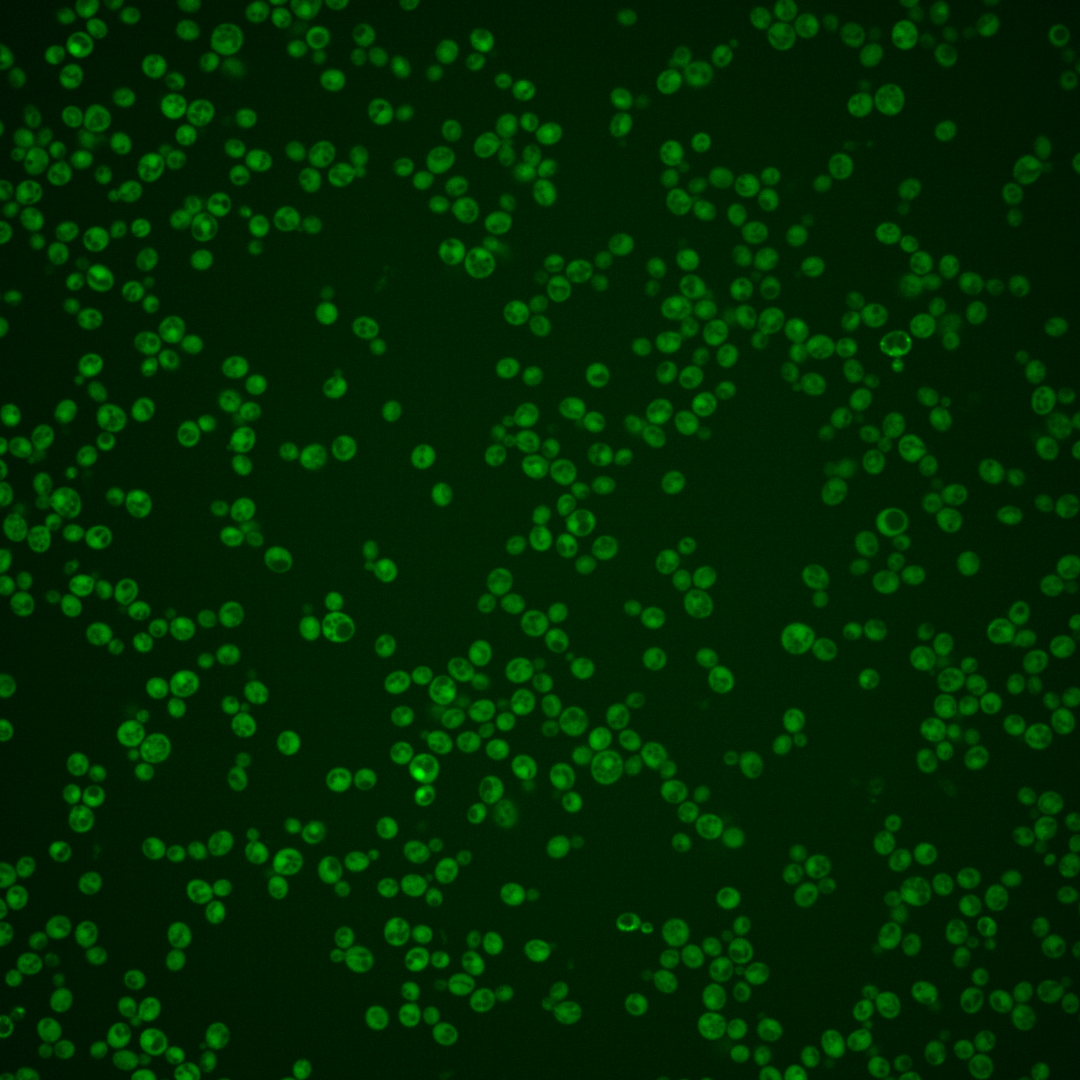

| Standard name | |
|---|---|
| Human Ortholog | |
| Description | Evolutionarily conserved 19S regulatory particle assembly-chaperone; proteasome-interacting protein involved in the assembly of the base subcomplex of the 19S proteasomal regulatory particle (RP); ortholog of human oncoprotein gankyrin, also known as p28, which interacts with the Rb tumor suppressor and CDK4/6 |
Micrographs




















































































Sub-cellular Localization
Yeast GFP Assignment
Protein Abundance
Localization Change
External localization resources
| ensLOC | DeepLoc | |||||||||||||||||||||||
|---|---|---|---|---|---|---|---|---|---|---|---|---|---|---|---|---|---|---|---|---|---|---|---|---|
| Localization | WT1 | WT2 | WT3 | RAP60 | RAP140 | RAP220 | RAP300 | RAP380 | RAP460 | RAP540 | RAP620 | RAP700 | HU80 | HU120 | HU160 | rpd3Δ_1 | rpd3Δ_2 | rpd3Δ_3 | WT1 | WT2 | WT3 | AF100 | AF140 | AF180 |
| Cortical Patches | 0 | 0 | 0 | 0 | 1 | 1 | 1 | – | 0 | 1 | 2 | 1 | 0 | 0 | 0 | 0 | 0 | 0 | 1 | 0 | 0 | 0 | 2 | 6 |
| Bud | 0 | 0 | 0 | 0 | 0 | 4 | 1 | – | 0 | 2 | 2 | 12 | 0 | 0 | 0 | 0 | 0 | 0 | 2 | 0 | 0 | 0 | 5 | 8 |
| Bud Neck | 0 | 0 | 0 | 0 | 0 | 0 | 0 | – | 0 | 0 | 0 | 0 | 0 | 0 | 0 | 0 | 0 | 0 | 0 | 0 | 0 | 0 | 1 | 1 |
| Bud Site | 0 | 0 | 0 | 0 | 0 | 0 | 0 | – | 0 | 0 | 0 | 0 | 0 | 0 | 0 | 0 | 0 | 0 | – | – | – | – | – | – |
| Cell Periphery | 2 | 1 | 4 | 9 | 16 | 4 | 23 | – | 11 | 12 | 20 | 30 | 2 | 7 | 7 | 8 | 5 | 5 | 0 | 0 | 0 | 0 | 0 | 0 |
| Cytoplasm | 192 | 137 | 225 | 298 | 447 | 388 | 662 | – | 358 | 417 | 469 | 491 | 295 | 447 | 530 | 225 | 165 | 172 | 274 | 138 | 224 | 225 | 551 | 471 |
| Endoplasmic Reticulum | 3 | 0 | 0 | 2 | 3 | 1 | 6 | – | 6 | 8 | 4 | 10 | 1 | 0 | 0 | 10 | 7 | 7 | 4 | 0 | 0 | 4 | 5 | 7 |
| Endosome | 1 | 0 | 1 | 0 | 1 | 0 | 0 | – | 0 | 1 | 1 | 2 | 0 | 0 | 0 | 1 | 0 | 0 | 4 | 0 | 1 | 0 | 2 | 5 |
| Golgi | 0 | 0 | 0 | 0 | 0 | 0 | 2 | – | 0 | 0 | 0 | 0 | 1 | 0 | 1 | 0 | 0 | 0 | 0 | 0 | 1 | 2 | 4 | 2 |
| Mitochondria | 5 | 0 | 0 | 4 | 3 | 42 | 18 | – | 48 | 45 | 111 | 118 | 0 | 0 | 0 | 1 | 0 | 0 | 3 | 1 | 1 | 2 | 1 | 5 |
| Nucleus | 7 | 0 | 0 | 1 | 3 | 3 | 11 | – | 13 | 15 | 19 | 15 | 0 | 0 | 0 | 8 | 2 | 0 | 0 | 0 | 0 | 0 | 0 | 0 |
| Nuclear Periphery | 8 | 0 | 0 | 1 | 0 | 0 | 0 | – | 0 | 5 | 2 | 7 | 0 | 0 | 0 | 0 | 0 | 0 | 0 | 0 | 0 | 1 | 0 | 1 |
| Nucleolus | 2 | 0 | 0 | 0 | 0 | 0 | 0 | – | 0 | 0 | 0 | 2 | 0 | 0 | 1 | 0 | 0 | 0 | 0 | 0 | 0 | 0 | 1 | 0 |
| Peroxisomes | 1 | 0 | 0 | 0 | 0 | 0 | 0 | – | 0 | 0 | 0 | 0 | 0 | 0 | 0 | 0 | 0 | 0 | 1 | 0 | 0 | 0 | 0 | 0 |
| SpindlePole | 0 | 0 | 0 | 0 | 0 | 0 | 1 | – | 0 | 0 | 0 | 0 | 0 | 0 | 0 | 0 | 0 | 0 | 3 | 0 | 0 | 0 | 4 | 4 |
| Vac/Vac Membrane | 7 | 0 | 1 | 1 | 18 | 8 | 114 | – | 84 | 104 | 91 | 122 | 2 | 2 | 1 | 14 | 7 | 2 | 6 | 0 | 0 | 2 | 2 | 3 |
| Unique Cell Count | 219 | 137 | 228 | 303 | 473 | 418 | 788 | 467 | 566 | 650 | 727 | 298 | 449 | 532 | 240 | 171 | 173 | 309 | 144 | 231 | 241 | 589 | 527 | |
| Labelled Cell Count | 228 | 138 | 231 | 316 | 492 | 451 | 839 | 520 | 610 | 721 | 810 | 301 | 456 | 540 | 267 | 186 | 186 | 309 | 144 | 231 | 241 | 589 | 527 | |
Yeast GFP Assignment
Protein Abundance
| Screen | WT1 | WT2 | WT3 | RAP60 | RAP140 | RAP220 | RAP300 | RAP380 | RAP460 | RAP540 | RAP620 | RAP700 | HU80 | HU120 | HU160 | rpd3Δ_1 | rpd3Δ_2 | rpd3Δ_3 | AF100 | AF140 | AF180 |
|---|---|---|---|---|---|---|---|---|---|---|---|---|---|---|---|---|---|---|---|---|---|
| Mean Cell GFP Intensity (1e-4) | 7.2 | 6.2 | 7.1 | 6.7 | 8.2 | 6.0 | 7.8 | – | 7.3 | 7.5 | 7.1 | 7.4 | 8.1 | 8.9 | 9.1 | 13.6 | 13.4 | 14.2 | 6.7 | 7.3 | 7.7 |
| Std Deviation (1e-4) | 8.1 | 0.9 | 1.0 | 1.4 | 1.6 | 1.2 | 1.6 | – | 2.0 | 1.6 | 1.6 | 1.7 | 1.4 | 1.6 | 1.7 | 3.3 | 2.5 | 3.0 | 1.5 | 1.8 | 1.6 |
| Intensity Change (Log2) | – | – | – | -0.08 | 0.21 | -0.26 | 0.13 | – | 0.04 | 0.07 | -0.01 | 0.04 | 0.19 | 0.32 | 0.35 | 0.93 | 0.91 | 0.99 | -0.08 | 0.03 | 0.12 |
Localization Change
| Localization | RAP60 | RAP140 | RAP220 | RAP300 | RAP380 | RAP460 | RAP540 | RAP620 | RAP700 | HU80 | HU120 | HU160 | rpd3Δ_1 | rpd3Δ_2 | rpd3Δ_3 |
|---|---|---|---|---|---|---|---|---|---|---|---|---|---|---|---|
| Cortical Patches | 0 | 0 | 0 | 0 | – | 0 | 0 | 0 | 0 | 0 | 0 | 0 | 0 | 0 | 0 |
| Bud | 0 | 0 | 0 | 0 | – | 0 | 0 | 0 | 0 | 0 | 0 | 0 | 0 | 0 | 0 |
| Bud Neck | 0 | 0 | 0 | 0 | – | 0 | 0 | 0 | 0 | 0 | 0 | 0 | 0 | 0 | 0 |
| Bud Site | 0 | 0 | 0 | 0 | – | 0 | 0 | 0 | 0 | 0 | 0 | 0 | 0 | 0 | 0 |
| Cell Periphery | 0.9 | 1.2 | 0 | 1.0 | – | 0 | 0 | 1.1 | 1.7 | 0 | 0 | 0 | 1.1 | 0 | 0 |
| Cytoplasm | -0.3 | -2.6 | -3.2 | -5.9 | – | -7.4 | -8.1 | -8.5 | -9.5 | 0.3 | 1.3 | 1.5 | -2.8 | -1.5 | 0.7 |
| Endoplasmic Reticulum | 0 | 0 | 0 | 0 | – | 0 | 0 | 0 | 0 | 0 | 0 | 0 | 0 | 0 | 0 |
| Endosome | 0 | 0 | 0 | 0 | – | 0 | 0 | 0 | 0 | 0 | 0 | 0 | 0 | 0 | 0 |
| Golgi | 0 | 0 | 0 | 0 | – | 0 | 0 | 0 | 0 | 0 | 0 | 0 | 0 | 0 | 0 |
| Mitochondria | 0 | 0 | 4.9 | 0 | – | 5.0 | 4.4 | 6.7 | 6.5 | 0 | 0 | 0 | 0 | 0 | 0 |
| Nucleus | 0 | 0 | 0 | 0 | – | 0 | 0 | 0 | 0 | 0 | 0 | 0 | 0 | 0 | 0 |
| Nuclear Periphery | 0 | 0 | 0 | 0 | – | 0 | 0 | 0 | 0 | 0 | 0 | 0 | 0 | 0 | 0 |
| Nucleolus | 0 | 0 | 0 | 0 | – | 0 | 0 | 0 | 0 | 0 | 0 | 0 | 0 | 0 | 0 |
| Peroxisomes | 0 | 0 | 0 | 0 | – | 0 | 0 | 0 | 0 | 0 | 0 | 0 | 0 | 0 | 0 |
| SpindlePole | 0 | 0 | 0 | 0 | – | 0 | 0 | 0 | 0 | 0 | 0 | 0 | 0 | 0 | 0 |
| Vacuole | 0 | 2.6 | 0 | 5.9 | – | 6.6 | 6.8 | 5.8 | 6.4 | 0 | 0 | 0 | 3.3 | 0 | 0 |
External localization resources
Images






























Protein Concentration and Protein Localization Data
| R1 | R2 | R3 | ||||||||||||||||
|---|---|---|---|---|---|---|---|---|---|---|---|---|---|---|---|---|---|---|
| G1 Pre-START | G1 Post-START | S/G2 | Metaphase | Anaphase | Telophase | G1 Pre-START | G1 Post-START | S/G2 | Metaphase | Anaphase | Telophase | G1 Pre-START | G1 Post-START | S/G2 | Metaphase | Anaphase | Telophase | |
| Concentration | 2.0006 | 2.8076 | 2.4327 | 1.7212 | 2.8588 | 2.6261 | 3.5866 | 4.9137 | 4.0262 | 3.6534 | 2.9519 | 4.1874 | 5.4072 | 7.1083 | 6.0604 | 6.2827 | 5.7767 | 6.1691 |
| Actin | 0.0381 | 0.0003 | 0.008 | 0.0002 | 0.0001 | 0.0099 | 0.0456 | 0.0009 | 0.0094 | 0.0012 | 0.0124 | 0.0059 | 0.0069 | 0.0004 | 0.0009 | 0.0042 | 0.0016 | 0.004 |
| Bud | 0.0009 | 0.0002 | 0.0003 | 0.0002 | 0.0001 | 0.0003 | 0.005 | 0.0227 | 0.0109 | 0.006 | 0.0011 | 0.0088 | 0.0002 | 0.0001 | 0.0002 | 0.0005 | 0.0025 | 0.0001 |
| Bud Neck | 0.0013 | 0.0003 | 0.0004 | 0.0003 | 0.0003 | 0.0027 | 0.0076 | 0.0002 | 0.0006 | 0.0009 | 0.0008 | 0.0012 | 0.0007 | 0.0001 | 0.0006 | 0.0011 | 0.0012 | 0.0008 |
| Bud Periphery | 0.0012 | 0.0001 | 0.0003 | 0 | 0 | 0.0002 | 0.0035 | 0.0034 | 0.0038 | 0.0023 | 0.0008 | 0.0039 | 0.0001 | 0 | 0.0001 | 0.0004 | 0.0019 | 0.0001 |
| Bud Site | 0.0023 | 0.001 | 0.0029 | 0.0001 | 0 | 0.0002 | 0.009 | 0.0089 | 0.0048 | 0.0013 | 0.0014 | 0.0004 | 0.0004 | 0.0013 | 0.0004 | 0.0016 | 0.0019 | 0.0001 |
| Cell Periphery | 0.0002 | 0.0001 | 0.0002 | 0 | 0 | 0 | 0.0005 | 0.0002 | 0.0003 | 0.0001 | 0.0001 | 0.0001 | 0.0001 | 0.0001 | 0 | 0.0001 | 0.0001 | 0 |
| Cytoplasm | 0.6931 | 0.8826 | 0.8234 | 0.9495 | 0.8945 | 0.8038 | 0.6598 | 0.7811 | 0.8247 | 0.7101 | 0.7148 | 0.8913 | 0.8879 | 0.9199 | 0.9228 | 0.9013 | 0.8867 | 0.9346 |
| Cytoplasmic Foci | 0.0256 | 0.0042 | 0.007 | 0.009 | 0.0139 | 0.0069 | 0.0323 | 0.0031 | 0.0096 | 0.0522 | 0.0685 | 0.0071 | 0.0123 | 0.0042 | 0.0077 | 0.0099 | 0.0053 | 0.0056 |
| Eisosomes | 0.0003 | 0 | 0.0001 | 0 | 0 | 0 | 0.0005 | 0.0001 | 0.0001 | 0 | 0.0001 | 0 | 0 | 0 | 0 | 0 | 0 | 0 |
| Endoplasmic Reticulum | 0.0079 | 0.0031 | 0.003 | 0.0019 | 0.0021 | 0.0065 | 0.0053 | 0.0013 | 0.0036 | 0.0014 | 0.0044 | 0.0021 | 0.0035 | 0.0011 | 0.0021 | 0.0025 | 0.0022 | 0.002 |
| Endosome | 0.037 | 0.0046 | 0.0075 | 0.0157 | 0.0067 | 0.0156 | 0.0447 | 0.001 | 0.0149 | 0.0379 | 0.0321 | 0.0044 | 0.0042 | 0.0017 | 0.0029 | 0.0069 | 0.0013 | 0.0036 |
| Golgi | 0.0157 | 0.0002 | 0.0043 | 0.0003 | 0.0001 | 0.0078 | 0.0083 | 0.0002 | 0.0088 | 0.0225 | 0.0149 | 0.0009 | 0.0008 | 0.0002 | 0.0004 | 0.0011 | 0.0002 | 0.0005 |
| Lipid Particles | 0.0184 | 0.0001 | 0.0042 | 0 | 0.0003 | 0.0017 | 0.0181 | 0.0013 | 0.0047 | 0.0065 | 0.038 | 0.001 | 0.0008 | 0 | 0.0005 | 0.0002 | 0.0001 | 0.0002 |
| Mitochondria | 0.0129 | 0.0001 | 0.0096 | 0.0002 | 0.0001 | 0.0029 | 0.0057 | 0.0026 | 0.0103 | 0.0062 | 0.0425 | 0.0049 | 0.0003 | 0.0001 | 0.001 | 0.0024 | 0.0002 | 0.0003 |
| None | 0.0468 | 0.0214 | 0.0231 | 0.0107 | 0.0099 | 0.0093 | 0.0443 | 0.0298 | 0.0279 | 0.0297 | 0.0282 | 0.0134 | 0.0703 | 0.039 | 0.0355 | 0.0309 | 0.0568 | 0.0271 |
| Nuclear Periphery | 0.0106 | 0.0025 | 0.0115 | 0.0015 | 0.0018 | 0.0092 | 0.0161 | 0.0024 | 0.0033 | 0.0024 | 0.0017 | 0.0031 | 0.0011 | 0.0007 | 0.0009 | 0.0021 | 0.0014 | 0.001 |
| Nucleolus | 0.0004 | 0.0002 | 0.0001 | 0 | 0.0001 | 0.0008 | 0.0017 | 0.0022 | 0.0011 | 0.0002 | 0.0002 | 0.0001 | 0.0001 | 0 | 0.0001 | 0.0002 | 0.0002 | 0 |
| Nucleus | 0.0696 | 0.0752 | 0.0812 | 0.0075 | 0.0675 | 0.1129 | 0.0448 | 0.1352 | 0.0478 | 0.0953 | 0.0035 | 0.0473 | 0.0022 | 0.0303 | 0.0192 | 0.0304 | 0.0343 | 0.0172 |
| Peroxisomes | 0.0046 | 0 | 0.0103 | 0.0001 | 0.0001 | 0.0006 | 0.0213 | 0.0002 | 0.0031 | 0.0157 | 0.0231 | 0.0004 | 0.0021 | 0.0001 | 0.0032 | 0.001 | 0.0001 | 0.0012 |
| Punctate Nuclear | 0.0075 | 0.0014 | 0.0005 | 0.0006 | 0.0016 | 0.0066 | 0.0107 | 0.0017 | 0.0078 | 0.0056 | 0.0062 | 0.0022 | 0.0053 | 0.0003 | 0.0008 | 0.0012 | 0.0011 | 0.001 |
| Vacuole | 0.0042 | 0.002 | 0.0015 | 0.0019 | 0.0006 | 0.0014 | 0.012 | 0.0011 | 0.0015 | 0.0016 | 0.0042 | 0.0009 | 0.0007 | 0.0003 | 0.0007 | 0.0014 | 0.0008 | 0.0004 |
| Vacuole Periphery | 0.0015 | 0.0002 | 0.0006 | 0.0005 | 0.0002 | 0.0006 | 0.0032 | 0.0004 | 0.0008 | 0.0008 | 0.0009 | 0.0003 | 0.0001 | 0 | 0.0001 | 0.0005 | 0.0001 | 0.0001 |
Sequencing Data
| R1 | R2 | |||||||||
|---|---|---|---|---|---|---|---|---|---|---|
| G1 Post-START | S/G2 | Metaphase | Anaphase | Telophase | G1 Post-START | S/G2 | Metaphase | Anaphase | Telophase | |
| Gene Expression | 56.2142 | 48.8163 | 52.2049 | 73.5908 | 63.5133 | 51.3674 | 68.9562 | 76.4248 | 81.3206 | 70.7024 |
| Translational Efficiency | 1.8768 | 1.7001 | 1.8386 | 1.6164 | 1.397 | 2.263 | 1.5557 | 1.8186 | 1.5453 | 1.4688 |
Hit Data
| Dataset | Hit |
|---|---|
| Protein Concentration | ✘ |
| Protein Localization | ✘ |
| Gene Expression | ✔ |
| Translational Efficiency | ✘ |
Endocytosis
| Temp | Actin Patch (Sac6-tdTomato) | Cortical Patch (Sla1-GFP) | Late Endosome (Snf7-GFP) | Vacuole (Vph1-GFP) |
|---|---|---|---|---|
| 37℃ | ||||
| RT |
Cell Cycle Omics
CYCLoPs (Nas6-GFP)
| Gene / Allele | Actin Patch (Sac6-tdTomato) | Cortical Patch (Sla1-GFP) | Late Endosome (Snf7-GFP) | Vacuole (Sac6-tdTomato) |
|---|
| Gene | Images |
|---|
| Gene | Images |
|---|
Images are not yet available
Images are not yet available